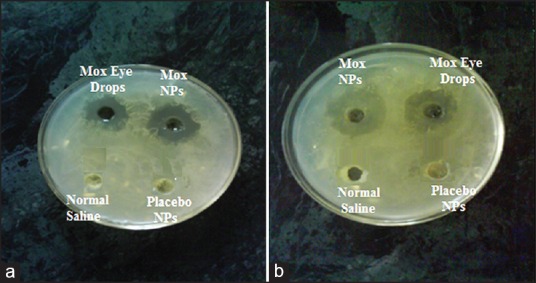
Figure 10

Abstract
Introduction:
Management of ocular surface disease by conventional formulation is limited by poor residence of drug at cul-de-sac of eye. To overcome this limitation, prolonged released mucoadhesive chitosan (CS)–dextran sulfate (DS) nanoparticles (NPs) were investigated for the prolonged topical ophthalmic delivery of moxifloxacin (Mox).
Methods:
Formulation was optimized by 3-factors (CS, DS, and Mox concentration), 3-levels (−1, 0, +1) Box-Behnken design. Optimized formulation was characterized for various in-vitro attributes, including particles size, zeta potential, shape and morphology, in-vitro release profile, corneal permeation, corneal retention, ocular tolerance test as well as antimicrobial activity.
Results:
Average hydrodynamic particle size of statistically optimized formulation was found to be 279.18 ± 15.63 nm with good polydispersity index, 0.367 ± 0.016 and positive zeta potential, +31.23 ± 1.32. NPs showed entrapment efficiency, 72.82 ± 3.6% and transmission electron microscopic analysis revealed a spherical shape of particles. Formulation exhibited biphasic release profile with an initial fast release (≈25% in 1st h) followed by sustained release (≈95% in next 24 h) following Korsmeyer–Peppas model with a nonFickian diffusion process. Mox loaded CS-DS NPs exhibited a significantly higher (P < 0.01), approximately 1.8-fold transcorneal permeation as well as significantly higher corneal retention (P < 0.01), around 4-5-fold when compared to free solution. Developed formulation exhibited safety profile comparable to normal saline, which was revealed by ocular tolerance test (Hen's egg test-chorioallantoic membrane). Mox-CS-DS NPs exhibited significantly high (P < 0.01) antimicrobial activity against Staphylococcus aureus and Pseudomonas aeruginosa.
Conclusion:
In-vitro and ex-vivo studies revealed that developed formulation could be a potential substitute for prolonged topical ocular delivery.
Keywords: Chitosan, dextran, moxifloxacin, nanoparticles, ocular delivery, transcorneal permeation
INTRODUCTION
Topical instillation is the most accepted, preferred and most convenient route for ocular drug delivery. Though, it is most challenging owing to its poor ocular bioavailability (<5%), primarily attributed to low corneal permeability, high tear turn over, transient residence time in the cul-de-sac, drug elimination via conjunctiva and sclera as well as naso-lachrymal drainage.[1] Poor ocular bioavailability compels for frequent instillation to achieve desired therapeutic effect, sometimes which may lead to undesirable side effects. Effectiveness of drugs is closely related to their ocular bioavailability that can be enhanced by improving corneal penetration and prolonging precorneal residence time.[2] A variety of approaches such as prodrug design, permeation enhancing formulations, longer residence formulations[3] inserts,[4] collagen shields,[5] and colloidal systems such as liposomes,[6] nanoparticles (NPs),[2] and nanocapsules[7] have been designed and investigated to improve ocular bioavailability. The use of polymeric NPs is a smart approach to enhance the ocular bioavailability of topically administered drugs as they offer inimitable features, while preserving the ease of delivery.[8,9] Polymeric NPs have been investigated to enhance the corneal and conjunctival penetration of therapeutic drugs and peptides, to sustain drug level and reduce the systemic side effects.[9,10] Most commonly investigated polymers in ocular delivery are poly(alkyl cyanoacrylates), polycaprolactone, and poly(lactic acid)/poly(lactic-co-glycolic acid) chitosan (CS), Eudragit RL/Eudragit RS, polystyrene, and poly(acrylic acid).[11] Polylactic-co-glycolic acid (PLGA) is an ideal biodegradable polymer for ocular delivery due to its biocompatibility, safety, regulatory approval, well tolerated in animal models and its potentialities in ophthalmology is well documented.[8,9,10] Several studies have revealed the effectiveness of PLGA NPs in enhancement of ocular bioavailability.[8,9,10,11,12] However, the short residence time of these nanosystems possess a major drawback in their therapeutic use.[13] Designing of a mucoadhesive carrier systems for ocular surface would be a sensible approach toward the management of surfacial ocular diseases. A wide range of mucoadhesive polymers reported in the literature, among them CS is promising polymer for topical ocular drug delivery owing to its unique properties such as mucoadhesion, tolerability, biodegradability and ability to enhance the paracellular transport of drugs.[14,15] In recent times, CS has been proposed as a biomaterial with promising potential for ocular drug delivery as its solutions revealed a prolonged corneal residence of antibiotics[16] and its coated nanocapsules exhibited more efficient intraocular penetration of drugs.[17,18] Prolonged residence time of CS NPs at the ocular mucosa of rabbits has been reported.[19] In addition, CS is reported to have antibacterial properties.[20] Hence, mucoadhesive CS NPs may have potential as colloidal drug delivery systems for the ocular mucosa.
Dextran sulfate (DS) is also a biocompatible, hemocompatible and nonimmunogenic polyanionic polymer comprises of highly branched polysaccharide with 1–6 and 1–4 glycosidic linkage. Electrostatic interaction between CS and DS leads to formation of DS-CS NPs. This method does not require any stabilizing or external cross-linking agents and exhibited good stability of formulations over those developed by using tripolyphosphate.[21] Various nanoformulations based on DS-CS NPs have been investigated for oral,[22] intravenous,[21] and controlled drug delivery.[23]
Moxifloxacin (Mox) is one of the fourth-generation broad spectrum fluoroquinolone antibiotics commonly used to treat ocular infections such as conjunctivitis, keratitis and keratoconjunctivitis.[24] It has been reported to have antimicrobial activity against Gram-negative bacteria like Pseudomonas aeruginosa equivalent to ciprofloxacin as well as ofloxacin, in addition it exhibited improved antimicrobial activity against Gram-positive bacteria also. Furthermore, Mox was found to be more effective than ciprofloxacin or levofloxacin against experimental keratitis in rabbits[25] and also showed better penetration into the inflamed ocular tissue of rabbits than ciprofloxacin, lomefloxacin, ofloxacin, or levofloxacin.[26] Hence, it could be better choice to treat the ophthalmic infections. However, it is commercially available as eye drops (0.5%) and requires frequent dosing for several days to achieve desired effect. Hence, the development of Mox encapsulated nanoformulations can be a sensible approach to enhance the ocular bioavailability, reduce the systemic side effects, dosing frequency, as well as better patient compliance. The present study is aimed at the development and statistical optimization of Mox encapsulated CS-DS mucoadhesive nanoparticulate formulation for ocular delivery using Design Expert® (Version 9.0, Stat Ease Inc., Minneapolis, MN) by employing Box-Behnken statistical design.
MATERIALS AND METHODS
Materials
The polymer CS (CS) (medium molecular weight, 200-800 cp, 1 wt.% in 1% acetic acid solution, deacetylation degree 75-85%) was procured from Sigma Aldrich. DS having molecular weight 15 kDa, was purchased from Bio Basic Pvt. Ltd. (Canada). Mox was given ex gratia by Promed export Pvt. Ltd., India. Ultrapure water was obtained with MilliQ equipment (Waters, USA). All other solvents and materials used were of analytical grade.
Preparation of buffer solutions
The composition of simulated tear fluid (STF), pH 7.4, was: Sodium chloride 0.670 g, sodium bicarbonate 0.200 g, calcium chloride dihydrate 0.008 g, and purified water q.s. 100 g.[27]
Preparation of chitosan–dextran sulfate nanoparticles
Solutions of CS and DS were prepared separately by dissolving the polymers in distilled water. Briefly, a known amount of CS was dissolved in a solution of 2% v/v acetic acid solution followed by vacuum filtration before the preparation of NPs. Mox loaded CS-DS NPs were prepared by ionic gelation method.[20] Briefly, the aqueous solution of CS containing Mox was added drop by drop to the DS solution under continuous magnetic stirring at 1000 rpm for 1 h. CS-DS NPs were formed spontaneously by ionic interaction between two polymers. The concentration range of polymers and drug under study was selected on the basis of preliminary experimentation where three types of phenomenon were occurred: Almost clear solutions, opalescent suspensions and aggregates. The zone of opalescent was appropriate for preparing CS-DS NPs. Formulation was further examined and optimized using Box-Behnken statistical design, Design Expert® (Stat-Ease Inc., Version 9.0) and the concentrations of CS, dextran, and Mox were used as per the design [Tables 1 and 2].
Table 1.
Independent and dependent variables included in Box-Behnken design

Table 2.
Observed responses in Box-Behnken design for Mox CS-DS NPs

Box-Behnken design
A design matrix consist of 17 experimental runs, independent variables included in the study were CS concentration (X1), DS concentration (X2), and amount of Mox (X3). The dependent variables were the particle size (Y1), encapsulation efficiency (Y2) and zeta potential (Y3). Independent variables and their level (low, medium, and high levels) under the study are shown in Table 1, which were selected on the basis of observations of preliminary experimentation. As per the recommendation of design expert, formulations were prepared and observations are shown in Table 2.
Optimization and model-validation
ANOVA provision available in the software was used to ascertain the statistical optimization of the polynomial equations obtained by Design Expert®. Software was used to identify the optimum values for particle size (minimum), entrapment efficiency (maximum), and zeta potential (positive). Formulations were prepared as per recommendation and evaluated for various response properties. The obtained values of responses were compared with that of the predicted values to calculate the percentage optimization error.
Characterization of developed formulation
particle size and zeta potential
Particles size, its distribution and zeta potential were determined using photon correlation spectroscopy (Zetasizer, HAS 3000; Malvern Instruments, Malvern, UK). The size distribution analysis was conducted at a scattering angle of 90° and at a temperature of 25°C. Zeta potential was measured using a disposable zeta cuvette. For each sample, the mean size and zeta potential were performed in triplicate.
Particle morphology
Particle morphological analysis was conducted by using transmission electron microscopy (TEM) (Philips CM-10, Eindhoven, The Netherlands). Formvar-coated copper grid (Plano GmbH, Wetzlar, Germany) was dipped into the NPs suspension, removed and air dried followed by staining with 2% w/v phosphor-tungstic acid solution. Digital Micrograph and Soft Imaging Viewer software (Olympus, Singapore) were used for image capturing and analysis.
Encapsulation efficiency
The entrapment efficiency of Mox-CS-DS NPs was determined by ultracentrifuge filtration method with slight modifications using Amicon R ultracentrifuge filtration tubes.[28] It consists of detachable donor and receiver compartment separated by a semi-permeable membrane (molecular weight cutoff of 12 KD). Diluted formulation was then placed in the upper compartment of the centrifuge filtration tube and centrifuged for 15 min at 3000 rpm. NPs were retained over the membrane. Filtrate was analyzed by UV-VIS, spectrophotometer (Double beam, Shimadzu, Japan). Entrapment efficiency was determined in triplicate and calculated as follows:

In-vitro release analysis
Nanoparticles were dispersed in 5 mL of ultrapure water and placed in a dialysis membrane bag with a molecular cutoff of 12 kDa, tied and placed into 50 mL of STF. The entire system was kept at 32 ± 0.5°C with continuous magnetic stirring (25 rpm), pH 7.4. At scheduled time intervals, 3 mL of sample was withdrawn and replaced with 3 mL fresh medium to maintain sink conditions. The amount of Mox in the release medium was determined by UV–VIS, spectrophotometer (Double Beam, Shimadzu, Japan). All measurements were conducted in triplicate. In-vitro release profile of mucoadhesive Mox-loaded CS-DS NPs was compared with release profile of the marketed Mox eye drops under similar conditions.
Ex-vivo transcorneal permeation study
Trans-corneal permeation potential of Mox through CS-DS nanoparticulate system was evaluated by using excised goat cornea with slight modification as reported.[9] Cornea was isolated from goat eyes procured from freshly slaughtered animals at a local abattoir. The study was carried out in a modified Franz diffusion chamber. The excised goat cornea was mounted between donor and receiver compartments facing epithelial surface to donor compartment of the Franz diffusion cell. The donor compartment was charged with 100 μL of commercially available marketed eye drops or Mox-CS-DS NPs suspended in 100 μL STF. The receiver compartment was filled with freshly prepared STF. Study was carried out at 32 ± 0.5°C. Periodically, samples were collected for up to 4 h and subjected to quantification of Mox by UV-VIS, spectrophotometer (Double beam, Shimadzu, Japan).
Corneal retention of chitosan–dextran sulfate nanoparticles quantitative and qualitative evaluation
Ex-vivo cornel retention of CS-DS NPs was performed with slight modification as reported.[29] It was performed on corneas isolated from goat eyes procured from freshly slaughtered animals at a local abattoir. 1 mL of STF, prewarmed to 32°C, was placed in donor compartments and 5 mL in receiver compartment for 15 min to stabilize the corneal tissue. The STF of the donor compartment was then replaced with 100 μL aqueous suspension of dye loaded CS-DS NPs (rhodamine equivalent to 2 μg) or rhodamine solution in STF and allowed for 1, and 4 h for possible interaction between formulations and cornea. After specified, time interval cornea was removed out and gently rinse with STF. Ocular retention of the formulation was quantitatively evaluated by spectrofluorimetric analysis of rhodamine. Before analysis, treated corneas were removed, homogenized followed by extraction with butanol as an extraction solvent. Resultant homogenate was centrifuged at 15,000 rpm for 15 min then subjected to quantitative analysis. The studies were performed in triplicate.
In order to evaluate the retention qualitatively, corneal tissue obtained from ex-vivo retention study were directly mounted keeping epithelial side up, on a glass slide and examined under fluorescent microscope (Nikon).
Ocular tolerance test (Hen's egg test-chorioallantoic membrane)
Ocular tolerability of the CS-DS NPs was evaluated by modified Hen's egg test-chorioallantoic membrane (HET-CAM) test as reported.[30] It has been reported to be a good qualitative tool for assessment of irritant potential of chemicals. Irritant potential of formulations is assessed in terms of adverse changes that occur in the chorioallantoic membrane (CAM) of the egg after exposure to test chemicals.[31] Briefly, freshly collected fertile hen's eggs were incubated at 37 ± 0.5°C and 40% ± 5% relative humidity for 3 days. Eggs were turned every day during incubation. Eggs not showing live embryo, intact yolk and showing damaged CAM were discarded. On day 10 of incubation, a window (2 cm × 2 cm) was made at equator of the egg. Test formulation (0.5 mL) was gently put onto the surface of the CAM. Sodium hydroxide (0.1 M) and normal saline were used as positive and negative control, respectively. After treatment (for 5 min), membranes were examined for the vascular responses and the time taken for injury. The scores were recorded according to the scoring schemes.[9]
Antimicrobial activity
The antimicrobial efficacy of the Mox loaded CS-DS NPs was evaluated against a Gram-positive microorganism (Staphylococcus aureus) and Gram-negative microorganism (P. aeruginosa) and compared with marketed eye drops as well as placebo NPs. Molten agar media was poured aseptically into sterilized petri plates, seeded with respective micro-organism and left to solidify. Cups were made by using sterilized stainless steel cup borer (4 mm diameter) and filled with 100 μL Mox eye drops (0.5%). Mox loaded NPs suspended in 100 μL normal saline (equivalent to 100 μL Mox eye drops) were also evaluated for same microbes. Similar procedure was followed for placebo NPs and normal saline. After inoculation of samples, plates were left at room temperature to diffuse the samples. Finally, plates were then incubated for 48 h at 37 ± 0.5°C. The diameter (mm) of the zone of growth inhibition was measured using a vernier caliper. Antimicrobial activity studies were conducted in triplicates.
RESULTS AND DISCUSSION
Preparation and optimization of moxifloxacin loaded chitosan–dextran sulfate nanoparticles by Box-Behnken design
Moxifloxacin loaded CS-DS NPs were formed instantaneously due to the co-acervation reaction between positively charged CS and negatively charged DS.[20] The co-acervation reaction involves the electrostatic interaction between the protonated amino groups of CS and sulfate groups of DS.[20] The size and entrapment efficiency of the prepared NPs was found to be affected upon varying the drug and polymer concentrations. Preliminary experiment was performed to screen the appropriate concentration of drug and polymer to achieve maximum entrapment, minimum particles size, and positive zeta potential. Selected concentration range of CS and DS were 0.025-0.10% w/v and 0.02-0.06% w/v, respectively and amount of drug taken in the range of 1-5 mg. Electrostatic interaction was reported to be the main mechanism for mucoadhesion between CS and mucin. In addition, hydrogen bonding and hydrophobic effects also imparts a significant role. This indicates that CS nanoformulation with a positive zeta potential would be more effective in-vivo than negatively charged CS.[32] Hence, at all the level (low, medium, and high), the dextran concentrations were kept lower than CS concentrations [Table 1] because at higher dextran concentration negative zeta potential was observed which can be attributed to sulfate group present in DS.
Employing of experimental design allows for testing a large number of independent variables simultaneously and reduces the number of experimental runs. A systematic optimization procedure involves the selection of an objective function, factors (independent variables) affecting responses (dependent variables) and investigation of relationship between responses. Objective functions for the present study were maximum encapsulation efficiency, minimum particles size and positive zeta potential. Box-Behnken design was employed for the statistical optimization of formulation parameters and evaluates the main effects, interaction effects and quadratic effects of the formulation ingredients on the encapsulation efficiency, particles size and zeta potential of NPs. A 3-factors, 3-levels design was used to explore the quadratic response and for constructing second order polynomial models using Design Expert (Version 9.0, Stat-Ease Inc.). The Box-Behnken design was selected for the optimization as it requires lesser number of experimental runs than other design at the same number of factors and same levels.[33]
The quadratic equations were generated from the observations of experiments by applying software, Design Expert version 9.0, Stat Ease Inc., Minneapolis, MN The generated equations are given below and in these equations only significant term has been included.

Design suggested the quadratic model for all the three responses, particles size (Y1), entrapment efficiency (Y2) and zeta potential (Y3). For the response Y1, the Model F-value 851.17 implies the model is significant (P < 0.0001). In this case X1, X2, X3, X1 X2, X2 X3, X12, and X22 are significant model terms. The lack of fit F value 0.28 was not significant (P < 0.837). Nonsignificant lack of fit is good for the model to fit. Similarly, for response Y2, the model F value 129.43 implies that the model is significant (P < 0.0001) and the lack of fit F value 0.38 (P < 0.775) is not significant. Model F value 1136.96 (P < 0.001) and the lack of fit F value 1.9 (P < 0.2715) was observed for zeta potential (Y3). Adequate precision represent the precision signal to noise ratio and must be >4 to navigate design space. Adequate precisions were found to be, 94.13, 39.82, and 117.19 for Y1, Y2, and Y3, respectively. Summary of regression analysis has been shown in Table 3.
Table 3.
Summary of regression analysis for the responses Y1, Y2, and Y3 for the quadratic model

Positive values reflect the synergistic relationship, while negative values represent an antagonistic effect. Synergistic effect means an effect that favors a higher value, and antagonistic effect means an effect that favors the lower values.[33] The relationship between dependent and independent variables can be better understood in Figures 1–3, the contour plots and response surface analysis generated by the same software, Design Expert version 9. Upon increasing the CS concentration particles size was increased which can be attributed to net increment in inter-molecular repulsive force due to the increased amino group of CS, however, reduction in particles size was observed upon increasing the dextran concentration, it can be attributed to electrostatic attraction between positive charge of CS and negative charge of dextran sulfate resulting into shrinkage of the particles. Positively charged particles exhibited bigger size, while negatively charged particles showed smaller size because of the charge on the molecules affects their expansion – contraction/folding – unfolding which decides their conformational structure and size.[34] Results are in corroboration with previous reports.[35,36,37] As in the case of CS, upon increasing the amount of drug, particles increased was which can also be attributed to the net increment in positive charge due to the cationic nature of drug.
Figure 1.

Contour plots and response surface diagrams representing the effects of different independent variables on the particle size of the chitosan–dextran sulfate nanoparticles
Figure 3.

Contour plots and response surface diagrams showing the effects of different independent variables on the zeta potential of the chitosan–dextran sulfate nanoparticles
Figure 2.

Contour plots and response surface diagrams showing the effects of different independent variables on the entrapment efficiency of the chitosan–dextran sulfate nanoparticles
Similar to particles size, CS, DS and drug concentration imparted a significant effect on entrapment efficiency. Upon increasing CS and DS concentration entrapment efficiency increased, it can be attributed to increase viscosity of CS that retarded the rate of diffusion as well as increased particles size possess a longer diffusion path length which resulting in net reduction in leaching of drug. Plausible mechanism behind the improved entrapment upon increasing DS concentration is the ionic interaction between drug (cationic) and DS (anionic) which improve the entrapment of drug within the particles by forming a complex. As the amount of drug was increased, entrapment efficiency was increased initially then decreased probably due to the insufficient number of polymer molecules (CS and DS) required to hold the drug molecules.
Surface charge of the particles is largely affected by the groups present on the surface of the particles. Net charge on the particles is the resultant of counterbalancing of groups present on the surface. Particles acquired the positive charge upon increasing the CS and drug concentration which can be explained by cationic nature of drug and polymer. While particles surface charge reverted (negatively charged) upon increasing the dextran concentration which can be attributed to sulfate group. From the above discussion it is concluded that size, entrapment, and zeta potential is adjustable which was further optimized by software design.
Optimization and validation of design
Design Expert® software was used to find out the optimum values of particle size (minimum), entrapment efficiency (maximum), and zeta potential. Suggested values of CS concentration, dextran concentration and amount of drug were 0.07% w/v, 0.055% w/v, and 3.92 mg, respectively. For these values, the predicted particle size, entrapment, and zeta potential were 278.46 nm, entrapment 73.45%, and 30.01. These predicted values for the independent variables were further validated by performing the experiment and obtained values of dependent variables (responses) were found to be 279.18 ± 15.63 nm and 72.83 ± 3.6% (n = 3) and 31.23 ± 1.32 mV. The obtained values are in the close proximity to the predicted values, and the low values of the standard deviation confirm the reproducibility of the method.
Characterization of developed formulations
Formulation developed for preliminary trial as well as recommended by Box-Behnken design was evaluated for their particle size, size distribution, entrapment efficiency and zeta potential. Particles sizes and entrapment efficiency were found to be in the range of 223.65-390.69 nm and 49.32-75.62%, respectively [Table 2]. Mox loaded CS-DS NPs exhibited positive as well as negative zeta potential, −12.36 to 50.36 mV. The particles size of statistically optimized formulation was found to be 279.18 ± 15.63 nm with a polydispersity index 0.367 ± 0.016 and its distribution is depicted in Figure 4a. Formulation was further characterized for zeta potential, shape and morphology. Zeta potential of the formulation was found to be + 31.23 ± 1.32 mv [Figure 4b] which can be attributed to the positive charge of CS as well as amine group of drug. The shape of particles was analyzed by TEM, which revealed discrete spherical shape and appearing dark [Figure 4c]. TEM images revealed the particles size from 200 nm to 300 nm. The result of TEM was in agreement with the particle size measured by dynamic light scattering. Entrapment efficiency of the optimized formulation was found to be 72.82 ± 3.6%.
Figure 4.

(a) Size distribution curve, (b) Zeta potential curve, (c) Transmission electron micrograph of statistically optimized formulation
In-vitro release studies
Moxifloxacin loaded CS-DS NPs exhibited an initial burst release (24.23 ± 1.82% in 1 h) followed by a more gradual and sustained release (94.36 ± 6.36% in 24 h) in STF s [Figure 5]. Marketed conventional eye drops exhibited very fast release; more than 92% within 30 min. Results are suggesting that the developed NPs can be a good tool for sustained drug release. Release pattern could be advantageous, initial burst release would be beneficial in terms of achieving minimum inhibitory concentration (MIC) of the drug in minimal time followed by sustained release to maintain the MIC for a prolonged period. The initial fast release of Mox can be attributed to rapid hydration of NPs due to the hydrophilic nature of CS and dextran as well as drug present at the surface of the particles. Sustained effect can be explained by the presence of the drug within the core of the particles. The release medium penetrates into the particles and dissolves the entrapped drug which further diffuses out into the dissolution media. Overall curve fitting [Table 4] revealed that the drug release from mucoadhesive CS-DS NPs followed Korsmeyer–Peppas model with a critical value of n 0.56 suggesting nonFickian diffusion process. Sustained effect can be further supported by the sequential process including polymer hydration, solvent penetration, drug dissolution and/or polymer erosion determining the drug release from hydrophilic matrices.[38]
Figure 5.

In-vitro release profile of statistically optimized formulation
Table 4.
In-vitro release model and their R2 obtained after fitting in-vitro release data

Ex-vivo transcorneal permeation study
The Mox loaded CS-DS NPs exhibited significant enhancement in permeation (33.36 ± 1.86%) than marketed Mox eye drops, 18.36 ± 1.2% in 4 h [Figure 6] which is approximately 1.8-fold (P < 0.01). Results are in agreement with the previous report.[39] Improved permeation can be attributed to prolonged retention owing to mucoadhesion of NPs because of ionic interaction between positively charged amino group of CS and negatively charged mucin available at the surface of the cornea.[40] In addition, endocytic uptake of NPs as well as improved transport of free drug via para-cellular route due to widening of tight junction in the presence of CS.[15]
Figure 6.

In-vitro transcorneal permeation profile of marketed eye drops and the optimized formulation
Corneal retention of chitosan–dextran sulfate nanoparticles quantitative and qualitative evaluation
In order to assess the quantitative corneal retention of the CS-DS NPs, rhodamine (fluorescent probe) content in cornea at 1 and 4 h of postincubation was determined and compared with retention of free rhodamine solution [Figure 7]. Results of the study showed remarkably different behavior of the Rd-NPs as compared to Rd solution. Rhodamine content in the cornea treated with Rd-CS-DS NPs was significantly high as compared to cornea treated with rhodamine solution (P < 0.01) at all the time point. It can be attributed to endocytosis of NPs, electrostatic interaction and mucoadhesion of CS NPs at the corneal surface.[19,41] However, in case of Rd-solution, Rd content was increased from 6.36% to 9.16% at 4 h. It can be attributed to more accumulation of Rd in between the layers of the cornea at 4 h of postincubation. Opposite to Rd-solution, Rd content got reduced from 32. 46 to 21.3% at 4 h into the cornea treated with Rd-CS-DS NPs. It can be explained by significant permeation of rhodamine across the cornea, in addition reduction in mucoadhesion as the time increased.
Figure 7.

Quantitative representation of corneal retention of rhodamine free solution and rhodamine loaded chitosan–dextran sulfate nanoparticles
Qualitative evaluation was done by using a fluorescent microscope, cornea after the treatments were visualized under ×20. A quite diffuse and less intense fluorescence was seen at the surface of the cornea treated with rhodamine solution. However, dense and intense fluorescence was observed at the surface of the cornea subjected to corneal Rd-CS-DS NPs [Figure 8]. It can be explained by similar mechanism as discussed above.
Figure 8.

Qualitative representation of corneal retention: (a) Rhodamine free solution at 1 h, (b) Rhodamine free solution at 4 h, (c) Rhodamine loaded chitosan–dextran sulfate nanoparticles (CS-DS NPs) at 1 h, (d) Rhodamine loaded CS-DS NPs at 4 h
Ocular tolerance test (Hen's egg test-chorioallantoic membrane)
Eye is a delicate organ and very sensitive to foreign materials or chemicals. Keeping the safety aspect in consideration, Mox loaded CS-DS NPs were evaluated by HET-CAM which is a rapid, sensitive and inexpensive test, as it is a borderline case between in-vivo and in-vitro condition hence, does not possess any conflict with the ethical and legal obligations. The CAM of the chick embryo is a complete tissue including veins, arteries, and capillaries and responds to injury with a complete inflammatory process similar to that induced in the conjunctival tissue of rabbit eyes.[31] The developed formulation was evaluated, and results were compared with negative control (normal saline) supposed to be practically nonirritant and positive control (0.1 M NaOH) supposed to be practically irritant [Figure 9]. The mean score of normal saline, 0.1 M NaOH and CS-DS NPs were found to 0, 4.66, 0 respectively. Zero score for developed formulations suggest its nonirritant potential. Nonirritant potential can be attributed to its biocompatibility and nonimmunogenicity of CS and dextran, the natural polymers.
Figure 9.

Microscopic images of Hen's egg test-chorioallantoic membrane after the treatment: (a) Normal saline, (b) Mox loaded chitosan–dextran sulfate nanoparticles, (c) 0.1 M NaOH
Antimicrobial activity
Antimicrobial activity of Mox loaded CS-DS NPs was compared with marketed eye drops at the same strength against Gram-negative (P. aeruginosa) and Gram-positive (S. aureus) bacteria by cup plate technique. Zone of inhibition was used as an assessment parameter. Zone of inhibitions for marketed eye drops and Mox-CS-DS NPs were found to be 13.43 ± 0.65 and 16.63 ± 0.83 mm, respectively, against P. aeruginosa. Similarly, Mox-CS-DS NPs exhibited higher zone of inhibition (11.86 ± 0.44 mm) as compared to Marketed eye drops (10.23 ± 0.36 mm) against S. aureus. In both the cases, zone of inhibition was found to be significantly high, P < 0.01. However, no zone of inhibition was observed in the case of normal saline as well as placebo NPs [Figure 10]. Higher zone of inhibition with respect to drug loaded NPs can be attributed to sustained release of drug from the NPs could help to maintain the MIC for a prolonged period of time.
Figure 10.
Representation of zone of inhibition for different formulations against: (a) Staphylococcus aureus and (b) Pseudomonas aeruginosa
CONCLUSION
Mox loaded CS-DS NPs were successfully developed and optimized by statistical design, Box-Behnken, Design Exper Softwere®. Formulation exhibited particles size in a nanorange with good uniformity and entrapment efficiency. In addition, formulation revealed prolonged release profile with significantly high transcorneal permeation as well as high corneal retention. Formulation exhibited comparable safety profile with normal saline and significantly higher antimicrobial activity than marketed eye drops against both Gram-positive and Gram-negative bacteria. Developed formulation could a viable substitute for conventional eye drops by virtue of its mucoadhesion, sustained drug release profile, and ease of administration. However, to bring it into clinically viable form stringent clinical studies are needed to be done.
Footnotes
Source of Support: Nil.
Conflict of Interest: None declared.
REFERENCES
- 1.Bourlais CL, Acar L, Zia H, Sado PA, Needham T, Leverge R. Ophthalmic drug delivery systems — recent advances. Prog Retin Eye Res. 1998;17:33–58. doi: 10.1016/s1350-9462(97)00002-5. [DOI] [PubMed] [Google Scholar]
- 2.de Campos AM, Diebold Y, Carvalho EL, Sánchez A, Alonso MJ. Chitosan nanoparticles as new ocular drug delivery systems: In vitro stability, in vivo fate, and cellular toxicity. Pharm Res. 2004;21:803–10. doi: 10.1023/b:pham.0000026432.75781.cb. [DOI] [PubMed] [Google Scholar]
- 3.Gaudana R, Jwala J, Boddu SH, Mitra AK. Recent perspectives in ocular drug delivery. Pharm Res. 2009;26:1197–216. doi: 10.1007/s11095-008-9694-0. [DOI] [PMC free article] [PubMed] [Google Scholar]
- 4.Ding S. Recent developments in ophthalmic drug delivery. Pharm Sci Technol Today. 1998;1:328–35. [Google Scholar]
- 5.Hill JM, O’Callaghan RJ, Hobden JA, Kaufman E. Corneal collagen shields for ocular drug delivery. In: Mita AK, editor. Ophthalmic Drug Delivery Systems. New York: Marcel Dekker Inc; 1993. pp. 261–75. [Google Scholar]
- 6.Bochot A, Fattal E, Grossiord JL, Puisieux F, Couvereur P. Characterization of a new ocular delivery system based on a dispersion of liposomes in a thermosensitive gel. Int J Pharm. 1998;162:119–27. [Google Scholar]
- 7.De Campos AM, Sánchez A, Gref R, Calvo P, Alonso MJ. The effect of a PEG versus a chitosan coating on the interaction of drug colloidal carriers with the ocular mucosa. Eur J Pharm Sci. 2003;20:73–81. doi: 10.1016/s0928-0987(03)00178-7. [DOI] [PubMed] [Google Scholar]
- 8.Araújo J, Vega E, Lopes C, Egea MA, Garcia ML, Souto EB. Effect of polymer viscosity on physicochemical properties and ocular tolerance of FB-loaded PLGA nanospheres. Colloids Surf B Biointerfaces. 2009;72:48–56. doi: 10.1016/j.colsurfb.2009.03.028. [DOI] [PubMed] [Google Scholar]
- 9.Gupta H, Aqil M, Khar RK, Ali A, Bhatnagar A, Mittal G. Sparfloxacin-loaded PLGA nanoparticles for sustained ocular drug delivery. Nanomedicine. 2010;6:324–33. doi: 10.1016/j.nano.2009.10.004. [DOI] [PubMed] [Google Scholar]
- 10.Mandal B, Halder KK, Dey SK, Bhoumik M, Debnath MC, Ghosh LK. Development and physical characterization of chloramphenicol loaded biodegradable nanoparticles for prolonged release. Pharmazie. 2009;64:445–9. [PubMed] [Google Scholar]
- 11.Guinedi AS, Mortada ND, Mansour S, Hathout RM. Preparation and evaluation of reverse-phase evaporation and multilamellar niosomes as ophthalmic carriers of acetazolamide. Int J Pharm. 2005;306:71–82. doi: 10.1016/j.ijpharm.2005.09.023. [DOI] [PubMed] [Google Scholar]
- 12.Vega E, Gamisans F, García ML, Chauvet A, Lacoulonche F, Egea MA. PLGA nanospheres for the ocular delivery of flurbiprofen: Drug release and interactions. J Pharm Sci. 2008;97:5306–17. doi: 10.1002/jps.21383. [DOI] [PubMed] [Google Scholar]
- 13.Davies NM, Farr SJ, Hadgraft J, Kellaway IW. Evaluation of mucoadhesive polymers in ocular drug delivery. II. Polymer-coated vesicles. Pharm Res. 1992;9:1137–44. doi: 10.1023/a:1015891419676. [DOI] [PubMed] [Google Scholar]
- 14.Badawi AA, El-Laithy HM, El Qidra RK, El Mofty H, El dally M. Chitosan based nanocarriers for indomethacin ocular delivery. Arch Pharm Res. 2008;31:1040–9. doi: 10.1007/s12272-001-1266-6. [DOI] [PubMed] [Google Scholar]
- 15.Paolicelli P, de la Fuente M, Sánchez A, Seijo B, Alonso MJ. Chitosan nanoparticles for drug delivery to the eye. Expert Opin Drug Deliv. 2009;6:239–53. doi: 10.1517/17425240902762818. [DOI] [PubMed] [Google Scholar]
- 16.Felt O, Furrer P, Mayer JM, Plazonnet B, Buri P, Gurny R. Topical use of chitosan in ophthalmology: Tolerance assessment and evaluation of precorneal retention. Int J Pharm. 1999;180:185–93. doi: 10.1016/s0378-5173(99)00003-4. [DOI] [PubMed] [Google Scholar]
- 17.Calvo P, Vila-Jato JL, Alonso MJ. Evaluation of cationic polymer-coated nanocapsules as ocular drug carriers. Int J Pharm. 1997;53:41–50. [Google Scholar]
- 18.Genta I, Conti B, Perugini P, Pavanetto F, Spadaro A, Puglisi G. Bioadhesive microspheres for ophthalmic administration of acyclovir. J Pharm Pharmacol. 1997;49:737–42. doi: 10.1111/j.2042-7158.1997.tb06103.x. [DOI] [PubMed] [Google Scholar]
- 19.De Campos AM, Sánchez A, Alonso MJ. Chitosan nanoparticles: A new vehicle for the improvement of the delivery of drugs to the ocular surface. Application to cyclosporin A. Int J Pharm. 2001;224:159–68. doi: 10.1016/s0378-5173(01)00760-8. [DOI] [PubMed] [Google Scholar]
- 20.Anitha A, Deepa N, Chennazhi KP, Nair SV, Tamura H, Jayakumar R. Development of mucoadhesive thiolated chitosan nanoparticles for biomedical applications. Carbohydr Polym. 2011;83:66–73. [Google Scholar]
- 21.Chen Y, Mohanraj VJ, Parkin JE. Chitosan–dextran sulfate nanoparticles for delivery of an anti-angiogenesis peptide. Lett Pept Sci. 2003;10:621–9. [Google Scholar]
- 22.Sarmento B, Ribeiro A, Veiga F, Ferreira D. Development and characterization of new insulin containing polysaccharide nanoparticles. Colloids Surf B Biointerfaces. 2006;53:193–202. doi: 10.1016/j.colsurfb.2006.09.012. [DOI] [PubMed] [Google Scholar]
- 23.Saboktakin MR, Tabatabaie R, Maharramov A, Ramazanov MA. Synthesis and characterization of superparamagnetic chitosan–dextran sulphate hydrogels as nano carriers for colon-specific drug delivery. Carbohydr Polym. 2010;81:37–376. [Google Scholar]
- 24.Speciale A, Musumeci R, Blandino G, Milazzo I, Caccamo F, Nicoletti G. Minimal inhibitory concentrations and time-kill determination of moxifloxacin against aerobic and anaerobic isolates. Int J Antimicrob Agents. 2002;19:111–8. doi: 10.1016/s0924-8579(01)00486-1. [DOI] [PubMed] [Google Scholar]
- 25.Dajcs JJ, Thibodeaux BA, Marquart ME, Girgis DO, Traidej M, O’Callaghan RJ. Effectiveness of ciprofloxacin, levofloxacin, or moxifloxacin for treatment of experimental Staphylococcus aureus keratitis. Antimicrob Agents Chemother. 2004;48:1948–52. doi: 10.1128/AAC.48.6.1948-1952.2004. [DOI] [PMC free article] [PubMed] [Google Scholar]
- 26.Yagci R, Oflu Y, Dinçel A, Kaya E, Yagci S, Bayar B, et al. Penetration of second-, third-, and fourth-generation topical fluoroquinolone into aqueous and vitreous humour in a rabbit endophthalmitis model. Eye (Lond) 2007;21:990–4. doi: 10.1038/sj.eye.6702414. [DOI] [PubMed] [Google Scholar]
- 27.Van Ooteghem MM. Biopharmaceutics of Ocular Drug Delivery. In: Edman P, editor. Boca Raton: CRC Press; 1993. pp. 27–41. [Google Scholar]
- 28.Pardeike J, Weber S, Haber T, Wagner J, Zarfl HP, Plank H, et al. Development of an itraconazole-loaded nanostructured lipid carrier (NLC) formulation for pulmonary application. Int J Pharm. 2011;419:329–38. doi: 10.1016/j.ijpharm.2011.07.040. [DOI] [PubMed] [Google Scholar]
- 29.Jain GK, Pathan SA, Akhter S, Jayabalan N, Talegaonkar S, Khar RK, et al. Microscopic and spectroscopic evaluation of novel PLGA-chitosan Nanoplexes as an ocular delivery system. Colloids Surf B Biointerfaces. 2011;82:397–403. doi: 10.1016/j.colsurfb.2010.09.010. [DOI] [PubMed] [Google Scholar]
- 30.Gupta H, Jain S, Mathur R, Mishra P, Mishra AK, Velpandian T. Sustained ocular drug delivery from a temperature and pH triggered novel in situ gel system. Drug Deliv. 2007;14:507–15. doi: 10.1080/10717540701606426. [DOI] [PubMed] [Google Scholar]
- 31.Spielmann H. Ocular irritation. In: Castle JV, Gomez MJ, editors. In Vitro Methods in Pharmaceutical Research. San Diego, CA: Academic Press; 1997. pp. 265–87. [Google Scholar]
- 32.Sogias IA, Williams AC, Khutoryanskiy VV. Why is chitosan mucoadhesive? Biomacromolecules. 2008;9:1837–42. doi: 10.1021/bm800276d. [DOI] [PubMed] [Google Scholar]
- 33.Zidan AS, Sammour OA, Hammad MA, Megrab NA, Habib MJ, Khan MA. Quality by design: understanding the formulation variables of a cyclosporine A self-nanoemulsified drug delivery systems by Box-Behnken design and desirability function. Int J Pharm. 2007;332:55–63. doi: 10.1016/j.ijpharm.2006.09.060. [DOI] [PubMed] [Google Scholar]
- 34.Gan Q, Wang T, Cochrane C, McCarron P. Modulation of surface charge, particle size and morphological properties of chitosan-TPP nanoparticles intended for gene delivery. Colloids Surf B Biointerfaces. 2005;44:65–73. doi: 10.1016/j.colsurfb.2005.06.001. [DOI] [PubMed] [Google Scholar]
- 35.Borges O, Tavares J, de Sousa A, Borchard G, Junginger HE, Cordeiro-da-Silva A. Evaluation of the immune response following a short oral vaccination schedule with hepatitis B antigen encapsulated into alginate-coated chitosan nanoparticles. Eur J Pharm Sci. 2007;32:278–90. doi: 10.1016/j.ejps.2007.08.005. [DOI] [PubMed] [Google Scholar]
- 36.Chen Y, Siddalingappa B, Chan PH, Benson HA. Development of a chitosan-based nanoparticle formulation for delivery of a hydrophilic hexapeptide, dalargin. Biopolymers. 2008;90:663–70. doi: 10.1002/bip.21055. [DOI] [PubMed] [Google Scholar]
- 37.Sharma S, Benson HA, Mukkur TK, Rigby P, Chen Y. Preliminary studies on the development of IgA-loaded chitosan-dextran sulphate nanoparticles as a potential nasal delivery system for protein antigens. J Microencapsul. 2013;30:283–94. doi: 10.3109/02652048.2012.726279. [DOI] [PubMed] [Google Scholar]
- 38.Chopra S, Patil GV, Motwani SK. Release modulating hydrophilic matrix systems of losartan potassium: Optimization of formulation using statistical experimental design. Eur J Pharm Biopharm. 2007;66:73–82. doi: 10.1016/j.ejpb.2006.09.001. [DOI] [PubMed] [Google Scholar]
- 39.Ameeduzzafar, Ali J, Bhatnagar A, Kumar N, Ali A. Chitosan nanoparticles amplify the ocular hypotensive effect of cateolol in rabbits. Int J Biol Macromol. 2014;65:479–91. doi: 10.1016/j.ijbiomac.2014.02.002. [DOI] [PubMed] [Google Scholar]
- 40.Porporatto C, Bianco ID, Correa SG. Local and systemic activity of the polysaccharide chitosan at lymphoid tissues after oral administration. J Leukoc Biol. 2005;78:62–9. doi: 10.1189/jlb.0904541. [DOI] [PubMed] [Google Scholar]
- 41.Dodane V, Amin Khan M, Merwin JR. Effect of chitosan on epithelial permeability and structure. Int J Pharm. 1999;182:21–32. doi: 10.1016/s0378-5173(99)00030-7. [DOI] [PubMed] [Google Scholar]
